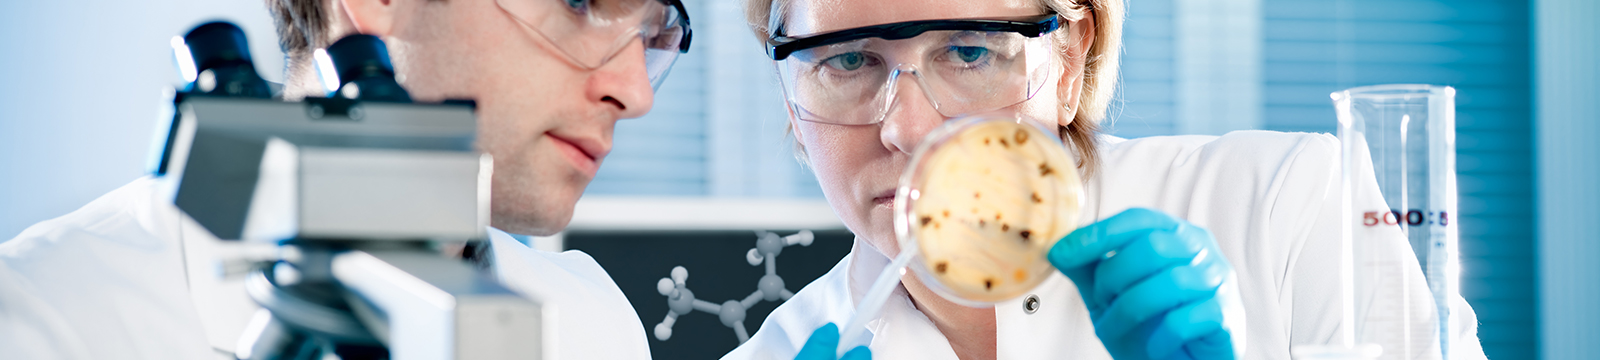

The Baker Company's SterilGARD e3 SG404 is a premium Class II Type A2 Biological Safety Cabinet, offering unmatched safety, comfort, and energy efficiency for your laboratory needs. With advanced technologies like StediFLOW and ReadySAFE, this unit enhances productivity by maintaining safety modes during periods of non-use, thus saving energy and extending filter life. The ergonomically designed cabinet ensures a comfortable work environment with minimal noise and vibration. Cleaning and maintenance are simplified with its one-piece work surface and detachable side panels. Used typically in Biosafety Levels 1-3 settings, it supports various personnel, product, and environmental protection needs with 70% recirculating and 30% exhausted airflow.
Key Features
- Class II Type A2 Biological Safety Cabinet
- StediFLOW airflow management system
- ReadySAFE idle mode feature
- 70% recirculating, 30% exhausted airflow
- Ergonomically advanced design for user comfort
- Membrane-sealed control panel
- Detachable side panels for easy maintenance
Specifications
- Voltage: 115V, 20 A, 60 Hz
- Exterior Dimensions: 61 H x 53 3/4 W x 30 11/16 D inches
- Interior Dimensions: 27 7/16 H x 46 W x 24 9/16 D inches
- Reducer of service downtime with quick filter replacement features
- Economic operation with significant energy savings
- Ideal for Biosafety Levels 1-3
Weight
Imperial: 720.0 Pounds
Metric: 326.59 Kilograms
Shipping Dimensions
Imperial: 37.2 lb x 64.8 lb x 105.6 lb
Metric: 94.49 cm x 164.59 cm x 268.22 cm
Harmonized Code
8414.60
Harmonized Code Details
Used for equipment utilizing airflow systems in laboratories, particularly applicable to biological safety cabinets such as this one.
We take great care packaging every item to ensure safe shipment to you. We use top quality packaging materials and equipment.
We DO NOT allow buyers to arrange their own shipping. However, we don't charge a fee for arranging the shipping for you. The cost of pallets or crates necessary for freight shipping may be extra. All orders are automatically shipped with added insurance that covers the FULL value of your purchase.
Standard Domestic Shipping
Standard shipping methods are chosen for you at our discretion, either by USPS, FedEx or UPS. Tracking numbers are emailed automatically at the end of the business day, once your shipment has left our facility. UPS overnight is only available until 12pm PST in order for us to ship on the same day. Please call to verify we've received your overnight request. Same day shipping overnight is not available during holidays or weekends. If you are sending to a PO Box, your purchase must be shipped via USPS, either First Class, Priority, or Parcel Post, without exception.
Freight
For larger and sensitive items that we have designated for freight shipment, please contact us for a shipping quote before you pay online. Items over 70 pounds will likely ship on a pallet or crate, whose costs will be the buyer's responsibility. Freight shipments will require a quote before you can make payment. Please contact us with:
- Your shipping address
- Confirm if your address is commercial or residential
- Inform us if you require a lift gate
Failure to provide this information could result in extra fees assessed by the carrier and we may bill you for the difference.
Damage Shipments
If your item arrives damaged by the shipping carrier, please take clear images before after opening your package to document the extent of the damage. The claim will require pictures of different angles of the box/crate before opening, and the damaged product(s) after opening. Email us immediately with your order number and item description, along with the images and we'll begin the claim process for you. We manage you claim at no extra cost. However, failure to provide adequate and timely information may result in a claim being denied, which will affect our ability to offer a refund.
Free Pick up
Will-call is available for those arranging local pick ups. Commercial carriers do not qualify as local pick up. We do not charge an extra fee if you want to pick your item up. The item will only be available as a loose load and will not be prepared for shipping. If you require a pallet for transport a fee may apply.
Special Packaging
We can have custom ISO certified heat-treated wood pallets, skids and crates built, if necessary. We do not charge a palletizing or packaging fee, but if your item requires a pallet, skid or crate, we will invoice you for the added costs.
International shipping
International orders will need to contact us and ask for a shipping quote. All International customers are responsible for their country's duties taxes. Please check with your country's requirements before purchasing.
We do offer international freight shipments. Simply contact us for a freight shipment quote according to the regular freight shipment instructions.
International Shipping Restrictions
In order to be eligible for standard international shipment, items must have a final sale price of at least $150. In order to be eligible for international freight shipments, items must have a final sale price of $1,500.
We do not offer international shipping to countries restricted by United States law.
Deductible
We are happy to arrange shipping for you, we DO NOT charge an extra fee for this service. When using us to arrange your shipping your item(s) are automatically shipped with added insurance that covers the FULL value of your purchase; you will be responsible for a 10% deductible.
If you are unsatisfied with your purchase in any way, please contact us first so we can rectify the situation immediately. You do not need to open a case on ebay or leave negative feedback, your complete satisfaction is more than enough motivation for us to do whatever it takes to make things right!
Please call our toll free number on our web site
Monday minus; Friday, 9am to 6pm PST
We bring integrity to the on-line market place. At REUZEit, customer service comes natural and is part of our core values. We have extensive knowledge about many common machines, if we do not know the answer right away, we will find out.
30-Day Warranty On PartWe accept:
- Visa, MasterCard, Discover and American Express
- PayPal
- Company checks (must cash before shipping)
- Wire transfers are encouraged and required for any international orders
- ACH transfers
- Cash on pick up
Customer Service
Open: Monday-Friday 9AM-6PM PST
REUZEit, LLC
28381 Vincent Moraga Dr
3rd Floor
Temecula, CA 92590
Phone: Please visit our web page for toll free phone number
The sale of this item may be subject to regulation by the U.S. Food and Drug Administration and state and local regulatory agencies. If so, do not bid on this item unless you are an authorized purchaser. If the item is subject to FDA regulation, an REUZEit representative will verify your status as an authorized purchaser of this item before shipping of the item.
You Need Equipment... We've Made It Easy and Affordable
The nation’s top lenders are ready to compete - with their best financing offers.
Financing is Smart
- AFFORDABLE MONTHLY PAYMENTS: Our network of competing lenders offer their lowest rates for 12 - 60 terms
- SMART MONEY MANAGEMENT:Preserve capital, manage cash flow and keep open lines of credit.
- 100% TAX DEDUCTIBLE: The total cost of most financed equipment purchases are 100% tax deductible.
Financing with REUZEit is Even Smarter
Instead of working with one lender and wondering if you're getting a good rate, we leverage competition among our network of the nation's top lenders to ensure you're getting thebest financing value available.
Here's how it works:
- APPLY: Submit one easy online application in seconds
- CHOOSE:The first 3 lenders to approve. your application submit their offers - choose the best one.
- EARN: Get your equipment, get to work, and start growing revenue.
When Lenders Compete, Your Business Benefits
REUZEit's Competing Lender Network
- Increased chances of being approved
- Informed business decisions
- One application Multiple offers.
- Lenders’ most competitive rates
- Side-by-side comparisons
- Faster approvals and funding